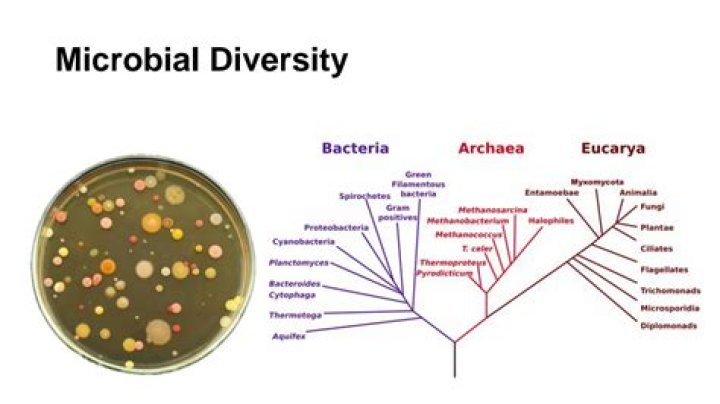

What is the microbial diversity
Microbial diversity can be defined as the range of different kinds of unicellular organisms, bacteria, archaea, protists, and fungi. Various different microbes thrive throughout the biosphere, defining the limits of life and creating conditions conducive for the survival and evolution of other living beings.
Why is microbial diversity important?
The diversity of microorganisms is critical to the functioning of the ecosystem, because there is the need to maintain ecological processes such as decomposition of organic matter, nutrient cycling, soil aggregation and controlling pathogens within the ecosystem (Kennedy 1999. Bacterial diversity in agroecosystems.
How is microbial diversity related to health?
Microbial diversity refers to the number of different species in your gut microbiome and how evenly they are spread out. The key to a healthy, resilient gut is having a high microbial diversity, meaning you have a high number of different species that are evenly spread across your gut microbiome.
How is microbial diversity measured?
For instance, microbial communities have often been characterized using divergence-based measures of β diversity to determine whether two communities are significantly different. These measures include the Phylogenetic test (P test) (Martin, 2002) and LibShuff (Singleton, et al., 2001, Schloss, et al., 2004).What is microbial diversity in soil?
Abstract. An increasing interest has emerged with respect to the importance of microbial diversity in soil habitats. The extent of the diversity of microorganisms in soil is seen to be critical to the maintenance of soil health and quality, as a wide range of microorganisms is involved in important soil functions.
How can microbial diversity be improved?
- Eat a diverse diet.
- Consume fermented foods with live microbes; they have at least a transient effect.
- Eat washed raw fruits and vegetables, which harbor environmental microbes (not recommended if you have difficulties digesting raw vegetables)
What are the types of microbial diversity?
Microbial diversity can be defined as the range of different kinds of unicellular organisms, bacteria, archaea, protists, and fungi. Various different microbes thrive throughout the biosphere, defining the limits of life and creating conditions conducive for the survival and evolution of other living beings.
Why microbial diversity is important in bioremediation?
Microbial bioremediation strategies are based on the consortia of diverse organisms that are indigenous to the polluted sites and possess immense metabolic potential. Isolating and purifying such indigenous microorganisms gives some knowledge of the microbial metabolites and the degradation processes.What factors may account for microbial diversity in a specific environment?
They rely on specific physical and chemical factors such as measuring temperature, pH, and salinity within a certain geography to formulate a comparison among microbial communities and the environment different species can tolerate.
What is meant by diversity with respect to organisms?Biological diversity is the variety of life on earth. This includes all the different plants, animals, and microorganisms; the genes they contain; and the ecosystems they form on land and in water. Biological diversity is constantly changing.
Article first time published onWhat is microbial activity in soil?
Abstract. Soil microbial activity that reflects microbiological processes of soil microorganisms is the potential indicator of soil quality, as plants rely on soil microorganisms to mineralize organic nutrients for growth and development.
How is soil microbial diversity measured?
Microbial diversity is measured by various techniques such as traditional plate counting and direct counts as well as the newer molecular-based procedures and fatty acid analysis.
How is microbial diversity an indicator of soil health?
It is concluded that microorganisms appear to be excellent indicators of soil health because they respond quickly to changes in the soil eco- system and have intimate relations with their surroundings due to their high surface to volume ratio.
What means microbial?
Microbial means relating to or caused by microbes. … the question of whether microbial life exists, or once existed, on Mars. Microbial infections now kill 17m people a year.
How are microbial species defined?
Currently the definition is as follows: A microbial species is a concept represented by a group of strains from a variety of sources, or by a population of strains, that contains freshly isolated strains, stock strains maintained in vitro for varying periods of time, and their variants (strains not identical with their …
What are good microbes?
Probiotics are live bacteria that are good for us, that balance our good and bad intestinal bacteria, and that aid in digestion of food and help with digestive problems, such as diarrhea and bellyache. Bacteria that are examples of probiotics are Lactobacilli and Bifidobacterium.
Why is microbial diversity important to the survival of humans and human health?
Exposure to a diverse range of microbes allows our bodies to mount an effective defensive response against pathogens. Another part of our immune system produces tiny armies of “memory cells” that maintain a record of all the pathogens our bodies encounter.
What is the effect of moisture on microbial growth?
Moisture may limit microbial activity in a wide range of environments including salt water, food, wood, biofilms, and soils. Low water availability can inhibit microbial activity by lowering intracellular water potential and thus reducing hydration and activity of enzymes.
What are the factors affecting microbial growth and survival?
Warmth, moisture, pH levels and oxygen levels are the four big physical and chemical factors affecting microbial growth. In most buildings, warmth and moisture are the biggest overall issues present. Dampness is a big player in the growth of fungi. Just like any living thing, water is essential to the life of microbes.
How do microbes benefit the environment?
The most significant effect of the microbes on earth is their ability to recycle the primary elements that make up all living systems, especially carbon, oxygen, and nitrogen (N). … Thus along with all these benefits, microbes greatly contribute in maintaining sustainability of environment.
Which microbial enzymes are used for biodegradation of pollutants?
The most representative enzymes involved in bioremediation include cytochrome P450s, laccases, hydrolases, dehalogenases, dehydrogenases, proteases, and lipases, which have shown promising potential degradation of polymers, aromatic hydrocarbons, halogenated compounds, dyes, detergents, agrochemical compounds, etc.
What is microbial bioremediation?
As defined, microbial bioremediation makes use of microorganisms and/or their derivatives (enzymes or spent biomass) to clean-up environmental contaminants [7, 9, 10]. … The natural existence of a large diversity of microbial species expands the variety of chemical pollutants that are degraded or detoxified.
What are the 3 types of diversity?
In a study of 180 Spanish corporate managers, we explored perceptions of diversity and found that depending on who is answering, diversity usually means one of three things: demographic diversity (our gender, race, sexual orientation, and so on), experiential diversity (our affinities, hobbies, and abilities), and …
What is a meaning of diversity?
It means understanding that each individual is unique, and recognizing our individual differences. These can be along the dimensions of race, ethnicity, gender, sexual orientation, socio-economic status, age, physical abilities, religious beliefs, political beliefs, or other ideologies.
What do you mean by biodiversity define it?
The term “biodiversity” refers to the variety of living organisms. Biodiversity brings together the different species and forms of life (animal, plant, entomological and other) and their variability, that is to say, their dynamics of evolution in their ecosystems.
Which is the microbial action?
Microbial activity is important for a series of soil reactions and functions, including organic matter decomposition, humus formation, nutrient cycling, aggregate formation and stabilization.
How is microbial activity measured in soil?
The rate of carbon dioxide production is commonly used as a measure of microbial activity in the soil. The traditional method of CO2 determination involves trapping CO2 in an alkali solution and then determining CO2 concentration indirectly by titration of the remaining alkali in the solution.
How can microbial activity be improved in soil?
- Add compost to your garden. …
- Plant in cover crops. …
- Keep your soil well watered. …
- Avoid physical disturbances. …
- Mulch your beds. …
- Avoid pesticides.
Is plant diversity associated with microbial diversity?
The current meta-analysis showed an overall insignificant correlation between plant diversity and soil microbial diversity (Fig. 3a, r = 0.173, CI = −0.006–0.341). Among the metrics of microbial diversity, microbial richness and Shannon diversity showed modest but positive correlation with plant diversity (Fig.
What bacteria is found in dirt?
- Bacterial biomass found in soil ranges from 300 to 3000 kg/ ha. …
- Common bacterial genera isolated from soil include Bacillus, Arthrobacter, Pseudomonas, Agrobacterium, Alcaligenes, Clostridium, Flavobacterium, Corynebacterium, Micrococcus, Xanthomonas, and Mycobacterium.
Is the microbiome in soil indicative of a healthy environment?
Maintaining a healthy soil microbiome isn’t just important for the plants, it’s critical for the environment. Soil high in organic matter with healthy microbial activity helps to trap excess carbon that would otherwise contribute to climate change.



